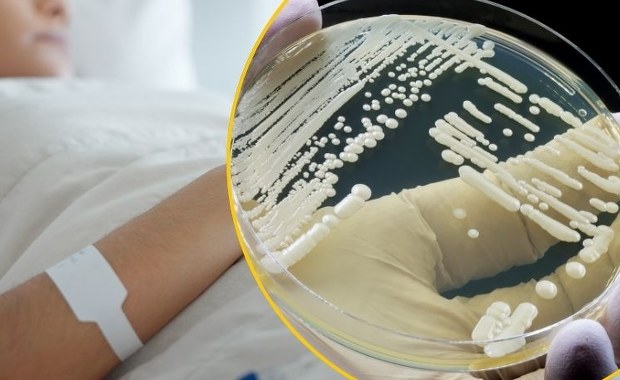
"Supergrzyb" rozprzestrzenia się po Europie. Eksperci biją na alarm

-
Piątek, 12 września 2025 (12:54)
-
Piątek, 12 września 2025 (11:34)
-
Czwartek, 11 września 2025 (15:25)
-
Czwartek, 11 września 2025 (14:10)
-
Czwartek, 11 września 2025 (11:51)
-
Czwartek, 11 września 2025 (11:32)
-
Czwartek, 11 września 2025 (11:10)
-
Środa, 10 września 2025 (15:28)
-
Środa, 10 września 2025 (14:34)
-
Środa, 10 września 2025 (14:21)
-
Środa, 10 września 2025 (13:02)
-
Środa, 10 września 2025 (12:15)
-
Środa, 10 września 2025 (11:50)
-
Środa, 10 września 2025 (10:31)
-
Środa, 10 września 2025 (10:07)
-
Środa, 10 września 2025 (09:46)